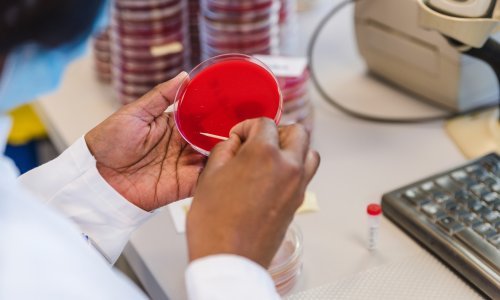
Nakon bolesti srca, bakterijske infekcije drugi su najveći uzrok smrti u svijetu. Ovo su dvije najsmrtonosnije bakterije

Bakterije otporne na antibiotike otkrivene su čak i u oblacima, prenošene vjetrom ponekad i na vrlo velike udaljenosti, otkriva francusko-kanadsko istraživanje
"Te bakterije obično žive na lišću ili u tlu", rekao je u petak glavni autor studije Florent Rossi u razgovoru za AFP.
"Otkrili smo da ih je vjetar nosio u atmosferu i da su mogle prevaliti na velike udaljenosti pa čak i obići zemaljsku kuglu na velikim visinama zahvaljujući oblacima", dodaje.
Kako bi došli do ovih zaključaka, istraživači sa Sveučilišta Laval u Quebecu i Sveučilišta Clermont Auvergne su pomoću "usisavača" velike brzine uzeli uzorke iz oblaka koji su se formirali iznad Puy de Dômea, uspavanog vulkana u središnjoj Francuskoj, a to su činili u razdoblju od rujna 2019. do listopada 2021.
Iz stanice za istraživanje atmosfere smještene na 1465 metara nadmorske visine, znanstvenici su analizirali ove uzorke u potrazi za genima otpornim na antibiotike.
Oblaci su sadržavali između 330 i više od 30.000 bakterija po mililitru vode, odnosno prosječno oko 8.000 bakterija po mililitru. U bakterijama je također identificirano 29 podtipova gena otpornosti na antibiotike.
Uz raširenu upotrebu antibiotika u zdravstvu, ali i u poljoprivredi, ova vrsta soja predstavlja "veliki zdravstveni izazov na globalnoj razini", navodi se u studiji. Svjetske zdravstvene vlasti u nekoliko su navrata istaknule rizike povezane s ovim bakterijama, zbog kojih je liječenje određenih infekcija sve složenije.
Studija, međutim, ne nudi zaključke o mogućim zdravstvenim učincima širenja bakterija koje nose gene otpornosti na antibiotike, procjenjujući da samo između 5 i 50 posto tih organizama može biti živo i potencijalno aktivno.
"Atmosfera je vrlo oštra za bakterije, a većina onih koje smo pronašli bile su bakterije iz okoliša, manje je vjerojatno da će biti štetne za ljude", rekao je Florent Rossi.
"Tako da se nema čega bojati kada hodate po kiši", ironično je dobacio znanstvenik te dodao da još "ne znamo mogu li se ovi geni prenijeti na druge bakterije".
Dubinsko praćenje atmosfere moglo bi, međutim, omogućiti lociranje odakle te bakterije dolaze i tako "ograničiti njihovo širenje", predlaže Rossi, uzimajući za primjer analize otpadnih voda s ciljem otkrivanja prisutnosti koronavirusa i drugih patogena.
Studija je objavljena u ožujskom broju časopisa "Science of The Total Environment".